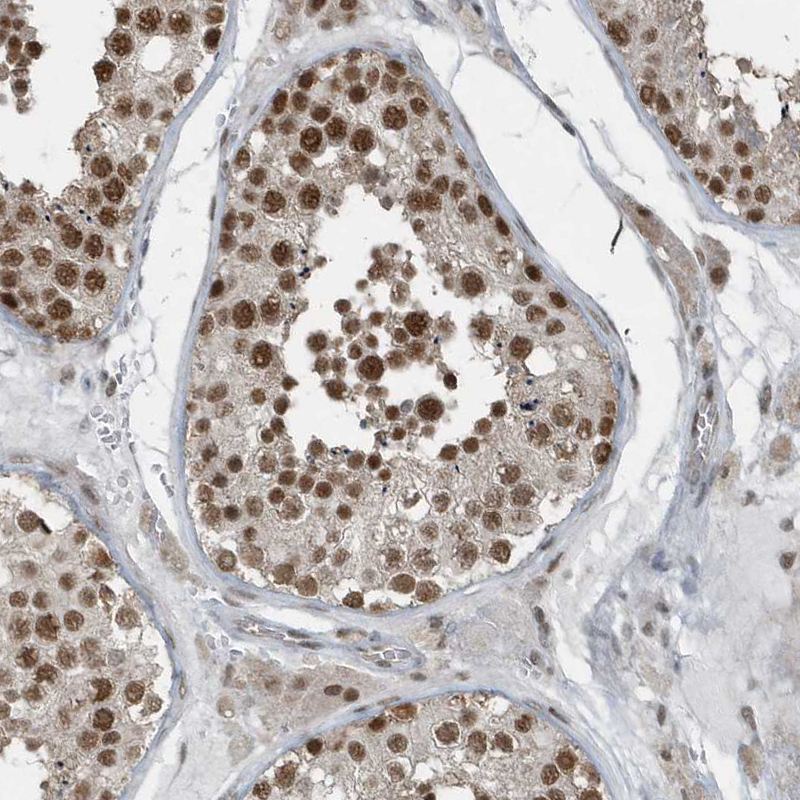
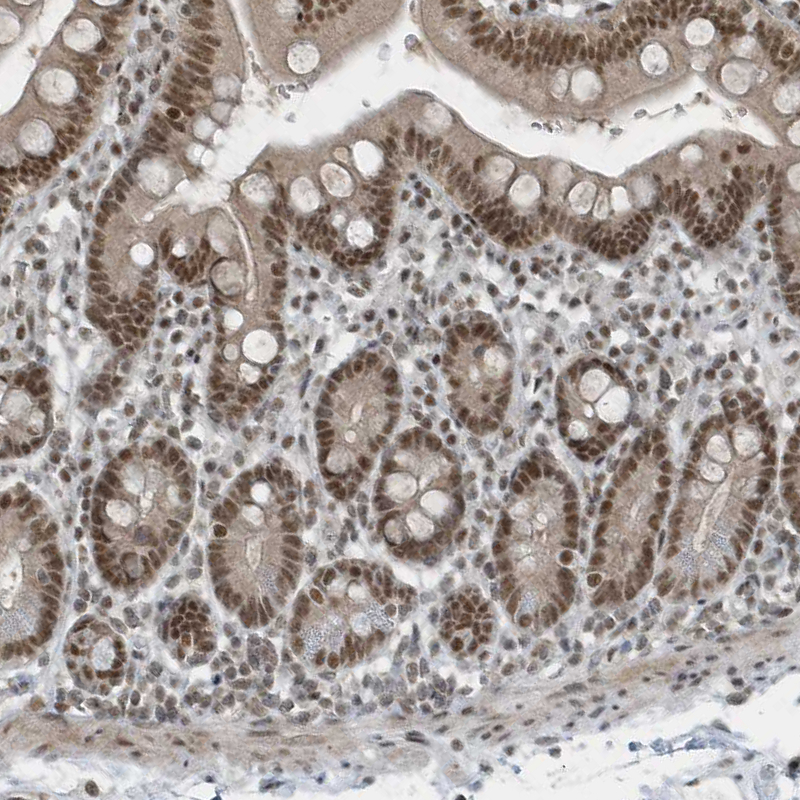

All products are designed for the highest possible performance and are manufactured using a standardized process to ensure the most rigorous levels of quality.
The Anti-YTHDC1 antibody (HPA036462) specifically targets YTH domain-containing protein 1 (YTHDC1), a nuclear protein involved in the regulation of RNA splicing and mRNA metabolism. YTHDC1 plays a pivotal role in post-transcriptional gene regulation by recognizing N6-methyladenosine (m6A) modifications on RNA, influencing processes such as alternative splicing, nuclear export, and RNA stability.
Importance in Research: YTHDC1 is a key component of the m6A RNA methylation pathway, which has emerged as a crucial regulator of gene expression in development, differentiation, and disease. Its nuclear localization and interaction with splicing factors make it an essential target for studies on RNA biology, epigenetic regulation, and cancer research.
The Anti-YTHDC1 (HPA036462) antibody is a valuable tool for researchers investigating:
- RNA splicing mechanisms
- m6A-mediated gene regulation
- Nuclear RNA-protein interactions
- The role of YTHDC1 in tumorigenesis and cell cycle control
Corresponding antigens
With Atlas Antibodies you get

From our facilities in Stockholm, Sweden we develop, manufacture and distribute highly advanced reagents to the Life Sciences community worldwide.

Our products are available to customers worldwide. From most locations, you can order our products from Atlas Antibodies. Please see more information about how to order here.

Learn how we validate our antibodies, how we secure their reproducibility, and why we apply enhanced validation. Our antibodies are validated in IHC, ICC-IF, and WB.